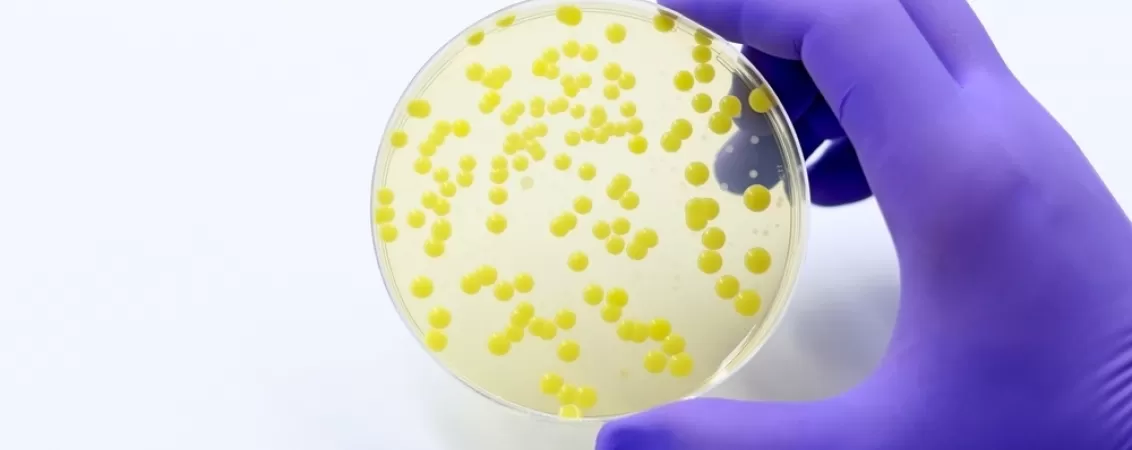
Proba de analliza a unei bacterii infectioase rezistente la antibiotic

Cocobacili: ce sunt și ce trebuie să știi despre ei
Ce sunt cocobacilii
Cocobacilii sunt bacterii a căror formă reprezintă o combinație de bacil (formă de tijă) și coci (formă ovală). În funcție de forma acestora, cocobacilii se pot clasifica în patru grupuri, cum ar fi:
- Bacil - fomă de tijă;
- Coccus - formă sferică;
- Spirochetă - formă de spirală;
- Vibrio - formă de virgulă.
Chiar și așa, anumite specii pot avea indivizi distincți când vine vorba de formă, aceștia putând lua forme filamentoase, ramificate sau de literă (V sau J).
Clasificarea cocobacililor se poate face și în funcție de capacitatea acestora de a absorbi colorația Gram, având astfel cocobacili Gram-pozitivi și cocobacili Gram-negativi. În urma testului de laborator, bacteriile Gram-pozitive prezintă un colorit violet, urmând ca cele Gram-negative să aibă o colorație roz, deoarece nu sunt capabile să absoarbă pigmentul.
Determinarea tipului de cocobacili este extrem de importantă pentru identificarea unei bacterii și, mai apoi, în punerea unui diagnostic corect de medicul specialist.
Unde se găsesc cocobacilii
Cocobacilii au o distribuire largă în mediul înconjurător, bacteriile putând fi prezente în sol, apă, alimente, sau animale, urmând ca, mai apoi, infecția să se transmită și la oameni. Persoanele afectate pot prezenta afecțiuni pulmonare, nosocomiale, vaginale sau ale gingiilor, în funcție de organul în care bacteria se instalează.
Tipuri de infecții cu cocobacili
Există diferite tipuri de infecții când vine vorba de cocobacili, deoarece aceste bacterii pot induce o gamă largă de afecțiuni, care cum ar fi: infecții ale tractului respirator, boli cu transmitere sexuală, meningită, infecții ale tractului urinar, infecții localizate la nivelul cavității bucale, dar și infecții pulmonare.
Infecția cu Chlamydia trachomatis
Chlamydia trachomatis este o bacterie Gram-negativă, ce poate induce o infecție de lungă durată, în multe cazuri chiar asimptomatică. Această afecțiune face parte din categoria bolilor cu transmitere sexuală (BTS). La femei, infecția cocobacilului se poate manifesta prin scurgeri vaginale diferite de cele obișnuite, disconfort în procesul de urinare sau chiar sângerări vaginale. La bărbați, manifestările infecției sunt adesea absente. Transmiterea acestor cocobacili se realizează pe cale sexuală, prin sex oral, vaginal sau anal. Tratarea infecției cu Chlamydia trachomatis nu este dificilă, însă este foarte important de menționat faptul că, lăsată netratată, această afecțiune poate provoca complicații care pot duce chiar la infertilitate.
Infecția cu Hemophilus influenzae
Hemophilus influenzae este un cocobacil anaerob facultativ, Gram-negativ, care are capacitatea de a induce o gamă largă de afecțiuni, de la meningită, la conjunctivită, pneumonie sau otită. În cazul meningitei, Haemophilus influenzae produce inflamarea creierului și a măduvei spinării. Netratată, meningita poate deveni letală pentru pacienți.
Infecția cu Coxiella burnetii
Coxiella burnetii este un cocobacil intracelular, Gram-negativ, responsabil de apariția febrei Q. Febra Q este o afecțiune rară, cauzată de inhalarea de praf contaminat cu Coxiella Burnetii, care poate provoca leziuni la nivelul inimii sau a altor organe.
Infecția cu Brucella spp.
Brucella spp. sunt cocobacili Gram-negativ care duc la instalarea în organism a brucelozei. Broceloza nu afectează doar oamenii, infecția putând fi diagnosticată și la animalele domestice. Ea poate să apară în urma contactului direct cu un animal infectat sau a inhalării de aer contaminat cu acest cocobacil.
Infecția cu Yersinia pestis
Yersinia pestis este un cocobacil Gram-negativ responsabil de apariția ciumei bubonice. Ciuma bubonică, sau Moartea Neagră, a dus la decesul a milioane de europeni în perioada Evului Mediu. În perioada 2010 - 2015, Organizația Mondială a Sănătății a raportat peste 3000 de cazuri de ciumă, care au dus la 584 de decese, dovedind astfel că, deși cazurile au scăzut de-a lungul timpului, afecțiunea este prezentă chiar și în zilele noastre.

Care sunt cauzele infecțiilor cu cocobacili
Cauzele infecțiilor cu cocobacili sunt multiple, în funcție de localizarea bacteriei, dar și de modul în care operează aceasta.
În cele mai multe situații, mediul înconjurător este responsabil de infectare și transmitere ca urmare a contactului cu animale, sol sau chiar inhalare de aerosoli contaminați, însă există și cazuri, cum ar fi de exemplu infecția cu Chlamydia trachomatis, când contactul sexual reprezintă factorul declanșator al afecțiunii, sau ciuma bubonică, în care persoanele sunt infectate de purici.
Indiferent de cauza afecțiunilor cu cocobacili, imunitatea reprezintă aliatul nostru principal în lupta cu boala.
Care sunt simptomele infecțiilor cu cocobacili
Simptomatologia infecțiilor cu cocobacili variază în funcție de localizarea acestora, însă adesea este caracterizată de febră, stare generală de rău, stări de greață, oboseală, vărsături sau amețeli.
În cazul brucelozei, simptomatologia poate include și dureri articulare, musculare sau ale spatelui, iar în cazul Febrei Q, ce prezintă simptomatologie asemănătoare gripei, se pot adăuga fotofobia (sensibilitatea la lumină), dar și apariția unor erupții la nivelul pielii (purpura).

Care sunt opțiunile de tratament pentru infecțiile cu cocobacili
Schemele de tratament pentru infecțiile cu cocobacili variază în funcție de tipul afecțiunii și de organele afectate. Chiar și așa, aceste infecții sunt tratate, în cele mai multe cazuri, cu ajutorul antibioticelor. Dacă infecția este una ușoară, medicul specialist poate recomanda antidiaretice, asociate cu o dietă sănătoasă.
Schema de tratament poate fi aplicată abia în urma punerii unui diagnostic de medicul specialist. În majoritatea cazurilor, specialistul poate cere și realizarea unei antibiograme, pentru a se evalua rezistența pacientului la antibiotice.
Alte informații despre infecțiile cu cocobacili
Când vine vorba de infecțiile cu cocobacili, este foarte important de amintit că există vaccinuri disponibile pentru acestea. Scopul lor este de a scădea riscul de infecție. În prezent, au fost dezvoltate și testate vaccinuri împotriva meningitei, a tusei convulsive, dar și a ciumei.
Bibliografie
- Hafner, L, et al. “Chlamydia Trachomatis Infection: Host Immune Responses and Potential Vaccines.” Mucosal Immunology, vol. 1, no. 2, 1 Mar. 2008, pp. 116-130, pubmed.ncbi.nlm.nih.gov/19079169/, https://doi.org/10.1038/mi.2007.19
- Nunes, Alexandra, and João P Gomes. “Evolution, Phylogeny, and Molecular Epidemiology of Chlamydia.” Infection Genetics and Evolution, vol. 23, 1 Apr. 2014, pp. 49-64, pubmed.ncbi.nlm.nih.gov/24509351/, https://doi.org/10.1016/j.meegid.2014.01.029
- “Plague | CDC Yellow Book 2024.” Cdc.gov, CDC.gov, 2024, wwwnc.cdc.gov/travel/yellowbook/2024/infections-diseases/plague
- Morroy, Gabriella, et al. “Fatigue Following Acute Q-Fever: A Systematic Literature Review.” PLoS ONE, vol. 11, no. 5, 25 May 2016, pp. e0155884-e0155884, www.ncbi.nlm.nih.gov/pmc/articles/PMC4880326/, https://doi.org/10.1371/journal.pone.0155884
- Khattak, Zoia E, and Fatima Anjum. “Haemophilus Influenzae Infection.” Nih.gov, StatPearls Publishing, 27 Apr. 2023, www.ncbi.nlm.nih.gov/books/NBK562176/
- Seladi-Schulman, Jill. “Your Guide to Coccobacilli Infections.” Healthline, Healthline Media, 27 Mar. 2018, www.healthline.com/health/coccobacilli#treatment. Accessed 5 Aug. 2024.
- “Coccobacilli: What Are They, Treatment, and More | Osmosis.” Osmosis, 2020, www.osmosis.org/answers/coccobacilli
Solicită o programare
Aici puteți să solicitați o programare pentru serviciile noastre de oriunde vă aflați, fără telefon și fără vizită în clinică.
Analizele cu bilet de trimitere în decontare cu Casa de Asigurări de Sănătate se recoltează doar în baza unei programări prealabile.
Articole din aceeași categorie

Stil de viaţă sănătos: recomandări, contraindicaţii
Stilul de viață sănătos a devenit unul dintre cele mai intens dezbătute subiecte, atât în comunitatea științifică, cât și în media (sub numeroasele ei forme), astfel încât informațiile sunt tot mai numeroase și tot mai variate, lăsând populația generală interesată de acest subiect confuză.Primul ele...

Celule epiteliale poligonale: ce sunt și ce trebuie să știi despre ele
Celulele epiteliale poligonale sunt structuri ce pot fi analizate în cadrul testării secreției vaginale. O secreție vaginală anormală diferă prin miros, consistență sau culoare și poate fi cauzată de un dezechilibru bacterian sau chiar de o boală cu transmitere sexuală....

Noradrenalina: ce este şi ce trebuie să ştii despre acest hormon
Noradrenalina, cunoscută și sub numele de norepinefrină, este un hormon și neurotransmițător esențial care joacă un rol cheie în răspunsul organismului la stres. Acesta face parte din răspunsul organismului „luptă sau fugi”, ajutând la pregătirea organismului pentru acțiune atunci când se confruntă ...